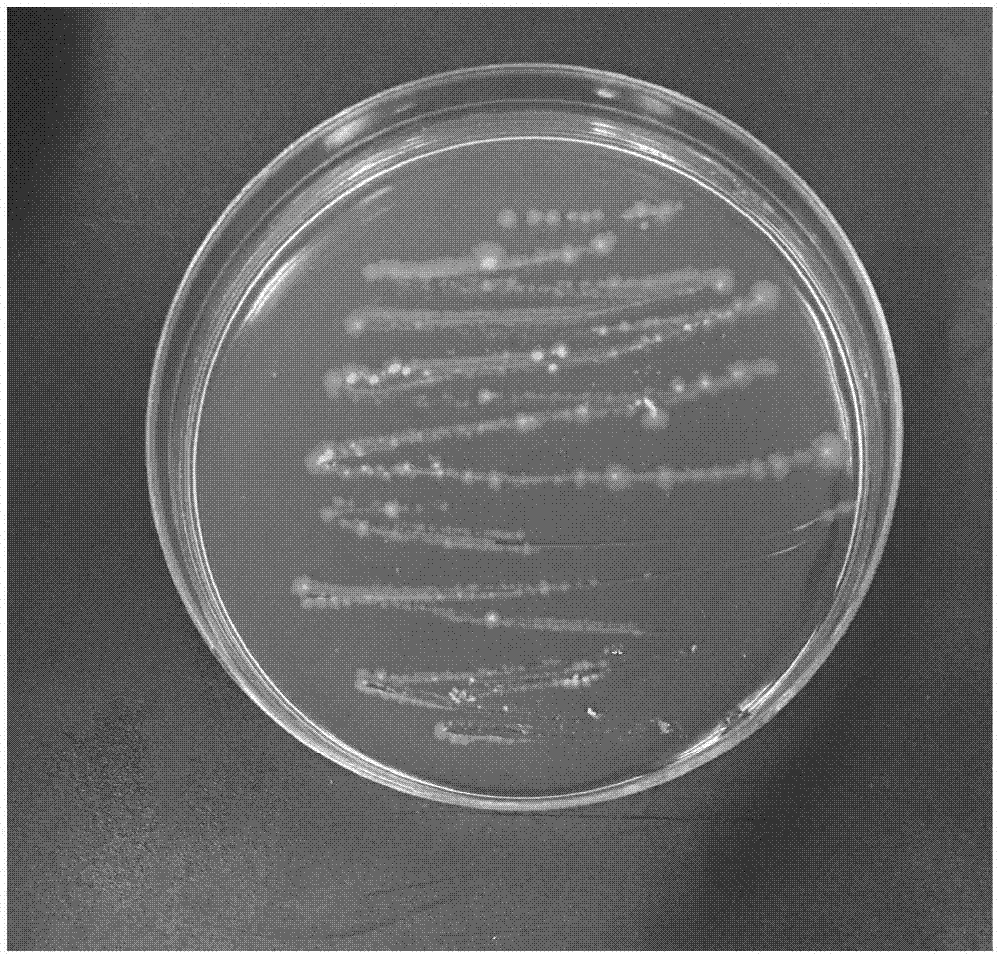
cn108330093a_一种诱导水稻抗稻瘟病的生防菌株及筛选方法和应用失效

稻瘟病菌分生孢子

田间水稻植株上如能见典型的梭形病斑,可初步确认为稻瘟病;如有些症状
图片尺寸458x353
梅雨季节,阴雨连绵,水稻稻瘟紧急预防,否则严重减产!_稻瘟病
图片尺寸664x447
雨研信息科技(上海)有限公司
图片尺寸900x450
入境邮件长沙海关查获稻瘟病菌想蒙混通关能让水稻减产一半
图片尺寸1090x774
科研人员在显微镜下观察到的水稻稻瘟病菌分生孢子.
图片尺寸600x456
谈谈水稻稻瘟病
图片尺寸640x360
一种稻瘟病菌孢子的制备方法
图片尺寸582x393
实拍水稻稻瘟病孢子
图片尺寸690x518
源于稻瘟病菌的真菌致病性基因moarrdc1及用途
图片尺寸934x1000
谈谈水稻稻瘟病
图片尺寸640x360
稻瘟病菌
图片尺寸960x720
水稻稻瘟病病菌研究进展_任鄄胜
图片尺寸2659x1457
cn108330093a_一种诱导水稻抗稻瘟病的生防菌株及筛选方法和应用失效
图片尺寸997x955
稻瘟病症状类型及特点 3. 病原及形态特点,生物学特性
图片尺寸680x510
稻瘟病菌的分生孢子在水稻叶表面开始萌发.电镜照片,放大2000倍.
图片尺寸641x552
水稻稻瘟病解析!
图片尺寸1440x810
global threats: the spread of crop pests
图片尺寸768x529
水稻稻瘟病抗性变化及抗性基因克隆的研究进展
图片尺寸700x350
稻瘟病
图片尺寸391x489
稻瘟病专用杀菌剂三环唑简析
图片尺寸635x344